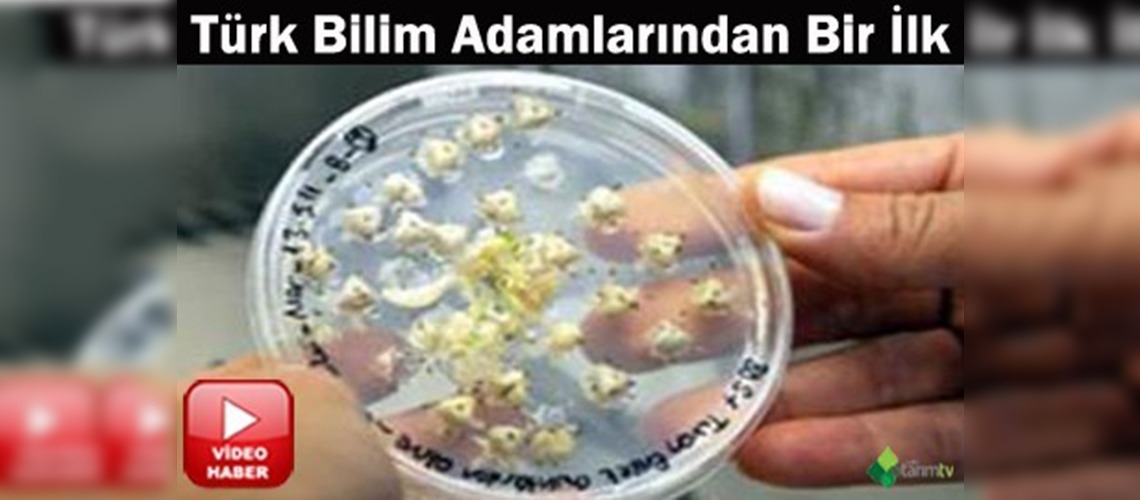

Dünyada ilk kez tozlanma ve döllenme olmaksızın sadece yumurta hücresinden saflaştırılmış pırasa ve soğan üreten Türk bilim adamları, bitkilerin biyoteknolojik yöntemlerle zirai hastalıklardan korunması için çalışma başlattı

Dünyada ilk kez tozlanma ve döllenme olmaksızın sadece yumurta hücresinden saflaştırılmış pırasa ve soğan üreten Türk bilim adamları, bitkilerin biyoteknolojik yöntemlerle zirai hastalıklardan korunması için çalışma başlattı. Pamukkale Üniversitesi (PAÜ) Bitki Genetiği ve Tarımsal Biyoteknoloji Merkezi (BİYOM) Müdür Yardımcısı ve Biyoteknolojik Islah Projeleri Koordinatörü Doç. Dr. Ali Ramazan Alan, Türkiye'nin tarımda bitkisel çoğaltma materyali olarak kullanılan genetik kaynaklarının hastalık ve zararlılardan arındırılarak korunması gerektiğini söyledi. Yüksek kaliteli tohumluk ve fidanların, tarımsal üretimin en önemli girdilerini oluşturduğunu belirten Prof. Dr. Ramazan Alan, gelişmiş ülkelerde uygulanmakta olan bitkileri virüslerden arındırma teknolojisini kendilerinin de uygulamaya başladıklarını bildirdi. Bitkilerin hastalık etmenlerinden arındırılmasının ancak biyoteknolojik uygulamalarla sağlanabildiğini belirten Prof. Dr. Alan, ilk olarak üzüm çeşitlerinin hastalık etmenlerinden arındırılması ve korunması amacıyla proje yürüttüklerini de sözlerine ekledi.

Kahramanmaraşlı genç girişimcilerin tavuk çiftliği kurma hayali...
Devamını Oku ->
Türkiye'nin önemli bal üretim merkezlerinden Sakarya'da...
Devamını Oku ->
Ispartalı elma üreticileri hasat sezonunu umutla bekliyor....
Devamını Oku ->
Siirt’te buğday hasadı şenlikle başladı. Kentte buğday üretiminin...
Devamını Oku ->
Çankırı İl Tarım ve Orman Müdürlüğü, “Kırsal Dezavantajlı Alanlar...
Devamını Oku ->
Kastamonu'da lise öğrencileri, atık ve doğadan topladıkları...
Devamını Oku ->
Samsun İl Tarım ve Orman Müdürlüğü’nün, “Altındaneler Toprakla...
Devamını Oku ->
Mardin'de orman yangınlarıyla mücadele ve ormancılık...
Devamını Oku ->